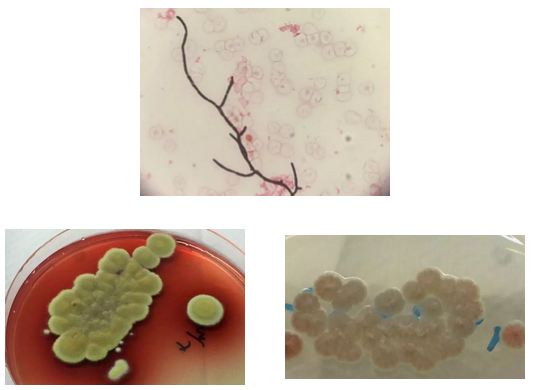
3.png

Fatal Talaromyces marneffei Infection in a Patient with Autoimmune Hepatitis
发布时间2019-08-15 丨 来源:丹娜生物 丨 浏览量 659
一例自身免疫性肝炎患者遭受致死性马尔尼菲蓝状菌感染的病例
香港玛丽女王医院的研究报告分析了一位因自身免疫性肝炎入院并感染马尔尼菲蓝状菌患者的病例。该患者因接受肝移植评估入院,在入院后第二天出现发热以及排尿困难等症状。临床初步拟诊为泌尿系统感染并经验性给予抗生素治疗。尽管后期抗感染方案升级为厄他培南与万古霉素,但患者感染仍然继续恶化,最终于入院后第5天去世。该患者在入院第2天行血培养,在3天后(患者去世当天)报告马尔尼菲蓝状菌阳性(培养结果如上图)。
在回顾性检查中使用该患者血清进行GM试验以及实验室自制马尔尼菲蓝状菌抗体检测,结果都为阴性;而G试验检测阳性,提示真菌感染可能性大。这也表明:对于怀疑马尔尼菲蓝状菌感染患者,应考虑真菌培养与多种血清学联合检测,形成优势互补,从而实现深部真菌感染早期快速诊断。
3-Fatal Talaromyces marneffei Infection in a Patient.pdf